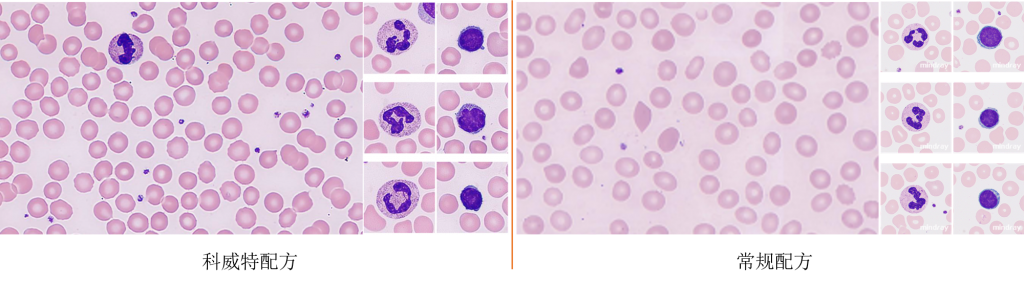

是否需要甲醇
- 推片机可选择关闭或开启甲醇预固定,但不管哪种方案,仪器都会在玻片进入染色盒之前加入甲醇进行润洗;
- 仪器需要每周/每月执行一次甲醇管路/染色盒维护;
- 可以使用无水乙醇,浓度≥99.7%,越高越好,建议品牌国药、西陇,维护参考甲醇方案。
染液要求
- 建议使用BASO的瑞氏-姬姆萨染液,批号BA4017C或BA4017MA;
- 其他类型或品牌染液可能导致阅片机分类错误,建议使用前进行测试。
缓冲液要求
- 建议使用BASO的磷酸盐缓冲液(pH6.8),批号BA4017D或BA4017MB;
- 手工配置建议方案:13.28 g KH2PO4 + 12.9 g Na2HPO4·12H2O + 4L H2O;
- Merck药片(P/N: 1.09468.0100 / 1.11373.0100 / 1.11374.0100)建议1片+10L水。
镜油要求
- 推荐BASO(P/N: BA-7003A / 7003B / 7003G)或Merck(P/N: 1.04699)。
微量血模式血膜短
- 全血模式仪器可检测粘度,依据HCT或粘度选择合适推片等级;
- 微量血模式无法检测粘度,无HCT信息时,默认使用等级8推片,当粘度较高时,血膜偏短;
- 建议手工录入微量血的HCT。
涂抹细胞过多
- 涂抹细胞是破碎的细胞;
- 可能由样本细胞状态(如放化疗、慢淋、长时间放置)、推片条件(角度过小、速度过快)、阅片区域(边缘尾部)等引起;
- 可将推片设置修改成“薄”和“+15%”。
异常细胞皱缩难辨认
- 阅片时细胞大小受推片影响,血膜干燥时若受到气流剪切力影响,细胞会被吹大;
- 细胞面积越大,厚度越小,内容物疏松程度越高,与染液反应越充分,颜色相对偏浅偏紫红;
- 要大要小取决于科室形态学负责人的习惯喜好;
- SC-120默认使用轻柔干燥的气流进行血膜干燥,若科室需要较大的细胞形态,可联系工程师申请安装风扇背板,安装前后效果比对如下图

红细胞立体感不强
- 使用BASO瑞氏-姬姆萨染液(P/N: BA4017MA / BA4017MB,下单备注科威特配方),与常规染液效果对比如下图。
质控血涂片不符合要求
- 执行阅片质控时,若非有核细胞(巨大和大血小板、涂抹细胞、沉渣等)占比超过30%,软件报警“质控血涂片不符合要求”;
- 该报警与阅片机性能没有关系;
- 建议在挑选质控片时先做一下外周血模式检测,挑选非有核比例少的样本。
- 升级LabXpert至1.57及以上,进入阅片设置-其他-阅片质控阈值设置,修改非有核报警阈值。
部分红系参数无结果
- MC-80目前还不支持部分红细胞参数的预分类,仅提供参数名称用于手工编辑,包括(棘形红细胞、咬痕红细胞、泡状红细胞、不规则收缩红细胞、镰形红细胞、球形红细胞、豪焦小体、帕彭海姆小体、寄生虫、红细胞凝集、红细胞缗钱状排列)
白细胞误分类
- MC-80的预分类符合率在说明书有宣称(白细胞≥85%,中性粒细胞≥90%,淋巴细胞≥90%,嗜酸性粒细胞≥80%,单核细胞≥80%,嗜碱性粒细胞≥70%,幼稚粒细胞≥70%,原始细胞和浆细胞≥70%,反应性淋巴细胞≥60%);
- 对于异常细胞预分类准确率较正常细胞低,主要是因为异常细胞形态多样,同时为了避免假阴性,因此会存在较多假阳性;
- 染色异常时也会导致分类错误,如染色过深导致嗜酸和中性分类错误;
- 若存在较多的淋巴误分类为有核红或中幼粒等情况,建议执行阅片机的亮度和白平衡校准。
阅片结果与人工、血常规差异大
- 根据ICSH建议,血液分析仪计数的粒子数更多,精密度更优,当不存在形态学报警或异常细胞导致血液分析仪无法提供准确分类的情况下,应使用血液分析仪结果进行报告,即使存在上述情况,镜检后发现镜检结果与血液分析仪结果相符,仍可使用血液分析仪结果进行报告;
- 若要评估阅片机分类准确性,应当以人工镜检结果为参考方法,而不是血液分析仪结果;
- 可调整推片设置(厚薄、长短)以增加阅片结果与血液分析仪的符合率。
PLT-M、PLT-I、PLT-O差异大
- 方法学不同,受干扰因素也不同;
- PLT-M仅用作血小板数量估计,本身精密度和准确度不如血液分析仪结果,对于三者间偏差也没有标准;
- 阅片机会自动识别PLT并计数,但是有时会将沉渣、真菌等杂质计入血小板,因此需要人工审核。
- 建议用户自定义估算系数。
杆状核分类标准
- 当细胞核完全分离或由一根细丝连接时(只有核膜没有染色质),可分类为分叶核中性粒细胞。
- 或者细胞核最窄处<1/3 最宽处即可认为是分叶核细胞, 反之则是杆状核细胞。
- 当难以辨别时,可分类为分叶核细胞。
涂抹分类标准
- 若涂抹的某些特征可被识别,则可当做正常细胞进行分类。
卵圆红标准
- 0.5<(短轴 / 长轴)≤0.78
与CV相比颗粒感低
- CV对细胞图像有一定的后处理,视觉上会有更强的颗粒感;
- MC-80细胞图像与镜下更加接近;
- 建议CV用户切换时花费1-2周进行磨合适应。
较显微镜下图像颜色深
- 由于成像方式差异,显微镜下图像会比较通透;
- 若阅片图像与镜下效果相差较大,建议执行阅片机亮度和白平衡校准。
自动阅片质控逻辑
- 未触发任何规则
- 无形态类报警
- WBC>7*10^9/L
- 所选时间段内首个符合规则样本
方法学比对方法
- 参考《WS/T246-2005 白细胞分类计数参考方法》、《H20-A2: Reference Leukocyte(WBC) Differential Count (Proportional) and Evaluation of Instrumental Methods》。
- 参考方法为人工镜检。
- Seq=√(pt·qt/nt+pr·qr/nr),p为某一类型细胞占比,q=1-p,n为计数细胞总数,t为实验方案,r为参考方法。
- 95%可信水平的系数为1.96,要求95%的样本在置信区间内,99%可信水平的系数为2.57,要求99%的样本在置信区间内。
WBC模式下血小板聚集检出率
- WBC模式下。MC-80通过10X镜头进行有核细胞的查找定位,同时捕获视野中较明显的非有核。继而使用100X镜头拍摄对应的细胞图片,包括视野中未被记录的非有核。
- 10X镜头分辨率较低,不能捕捉到所有的非有核。
- 当血小板染色或形态变化时,会造成WBC模式下聚集检出率的变化。
- 推荐使用PLT-Pro模式进行聚集的排查。
PLT-Pro模式血小板聚集漏检
- Pro模式对于缺颗粒或染色过浅的聚集团有可能漏检。
- 保证染色正常。
- 当血小板减低,Pro模式未发现聚集团时,建议人工复片。
异常WBC漏检
- MC-80外周血WBC模式工作区域无法覆盖边缘和尾部。
- 当异常细胞浓度极低,只分布在边缘和尾部时,MC-80无法检出。
- 建议对于低值白细胞设置复检方式为阅片,增加WBC阅片数量。
- 当WBC异常减低,且阅片未发现异常细胞时,建议人工复片。
红细胞参数重复性
- MC-80通过10X镜头定位红细胞50%重叠区域到单细胞层为工作区域。
- 玻片进样位置、涂片表面油渍、划痕等因素会影响算法判断。
- 不同视野异常红细胞比例差异大。